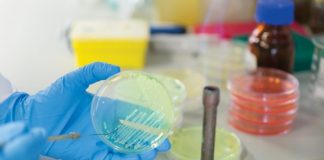
Budget 2025: Biotech stakeholders welcome focus on R&D, digitalization

Tag: Budget
Budget 2025: Biotech stakeholders welcome focus on R&D, digitalization
Will the budget propel India's biotech industry toward becoming a global powerhouse, or are there gaps that need to be addressed? Here’s how the sector is responding.
Budget 2025: Hospital industry welcomes govt’s focus on patient welfare &...
Industry leaders have lauded the government’s commitment to strengthening primary healthcare, boosting medical education, and fostering innovation
Budget 2025: Agri stakeholders welcome govt’s focus to bolster rural economy...
Experts and industry leaders share their reactions
Budget 2025 is reassuring, instils confidence: Kiran Mazumdar Shaw
Chairperson and Managing Director of Biocon welcomed the various initiatives made by the government
Budget 2025: OPPI hails initiatives for inclusive & innovation-driven healthcare landscape
Anil Matai, Director General, OPPI expresses commitment towards working alongside policymakers to further strengthen the sector and address areas that require continued attention
Budget 2025: Govt makes bigger allocations for health, education & R&D;...
The allocations are significant but not on expected lines for healthcare and biotechnology industry
Govt’s share in total health expenditure jumps to 48.0 % from...
The Economic Survey has highlighted that under Ayushman Bharat Digital Mission (ABDM) 72.81 crore Ayushman Bharat health Accounts have been created
Budget 2025 Expectations: Healthcare industry seeks significant investments
Public healthcare expenditure has increased from 1.13% to 1.84% of GDP over the same period, but experts believe this is far from the target of 3% by 2030
Budget 2025: Healthcare industry calls for bigger allocation, better incentives
Industry leaders expect incentives for digital health adoption and interoperability between private and public healthcare systems
Budget 2025: MedTech industry leaders seek tax incentives, encouraging policies
The leading stakeholders of the Indian medical devices industry share their expectations from the union budget 2025 slated for 1st February